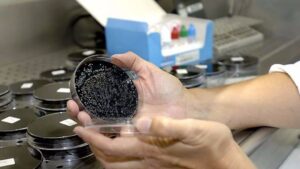

Noticias del mes de noviembre de 2017
La Policía Nacional ha detenido en Sevilla a un joven de 24 años de edad por presuntos abusos sexuales sobre 15 menores con los que contactó a través de las redes sociales con pretextos como los videojuegos y a los que habría pagado cuantías de entre cien y 400 euros, a cambio de tocamientos y […]
Dos personas de edad avanzada y con una patología grave previa han muerto en Llinars del Vallès (Barcelona) en los últimos días por un brote de legionela que ha afectado a otros tres ancianos, actualmente ingresados, ha informado la Conselleria de Salud de la Generalitat en un comunicado. 194
Un hombre de unos 40 años de edad ha fallecido tras caer desde unos 12 metros de altura en un edificio del Coll d’en Rabassa, en Palma. 139
Un hombre de unos 40 años de edad ha fallecido tras caer desde unos 12 metros de altura en un edificio del Coll d'en Rabassa, en Palma. 516
Ninguna de las tres cárceles de Balears tiene servicio de orientación jurídico-penitenciaria (SOAJP) para presos para que los internos reciban asesoramiento sobre su situación en prisión. 202
Los exconsellers de Interior y Trabajo de la Generalitat, Joaquim Forn y Dolors Bassa, han llegado este martes a Barcelona procedentes de Bruselas, donde se habían desplazado con el ex presidente Carles Puigdemont, y al llegar un grupo de personas les ha recibido al grito de «a prisión». 205
La Fundación Turismo Palma 365 ha presentado el manual de señalización turística de la ciudad cuyo objetivo es favorecer la descongestión de algunas zonas de la ciudad mediante la canalización correcta de los flujos turísticos. 365
El PP en el Consell de Mallorca, por medio de la consellera Catalina Soler, pedirá al equipo de gobierno insular que modifique la actual ley de caza para, de este modo, poder dar cumplimiento al compromisoverbal del conseller de Desenvolupament Local, Joan Font Massot, en el Pleno del pasado mes de septiembre de que la […]
El Ayuntamiento de Palma, junto al Consistorio de Llucmajor y el Consorcio Playa de Palma, ha presentado el proyecto del torrent dels Jueus, que contará con hasta 58 especies diferentes de plantas con el fin de «naturalizar y mejorar el espacio público». 1.063
Se llama Sayfullo Saipov, uzbeco de 29 años y conductor de Uber. Es el hombre que este martes ha atropellado con una furgoneta a una multitud de personas dejando ocho muertos y más de diez heridos. La Policía cree que era un lobo solitario ya que en las inmediaciones del escenario del atropello han encontrado […]
Se llama Sayfullo Saipov, uzbeco de 29 años y conductor de Uber. Es el hombre que este martes ha atropellado con una furgoneta a una multitud de personas dejando ocho muertos y más de diez heridos. La Policía cree que era un lobo solitario ya que en las inmediaciones del escenario del atropello han encontrado […]
El Palma Futsal empata a uno en un batallado partido en la cancha del Aspil-Vidal Ribera Navarra en un partido que pudo decantarse del lado isleño si Paradynski hubiera acertado en la última acción del encuentro. De esta manera, el Palma resuelve su primer partido de la minigira por tierras navarras con un meritorio empate […]